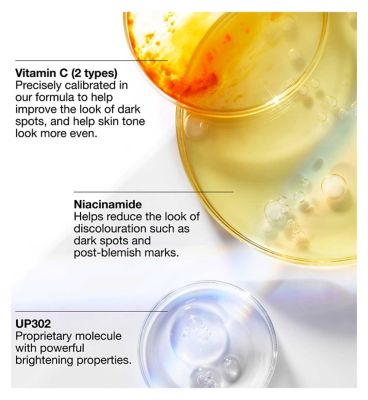

Clinique Even Better Clinical™ Dark Spot Clearing Serum 30ml
Frequently Bought Together
Estimated Shipping Time
Lagos: 1 – 2 Business Days.
Rest of Nigeria: 3 – 5 Business Days.
How To Use
Shipping & Returns
Reliable Nationwide Shipping from Lagos
We understand the importance of timely delivery. All orders are processed at our Lagos warehouse and shipped directly to your doorstep in any state across Nigeria.
Shipping Rates by State:To ensure full transparency, please find your location below for the applicable shipping fee:
Lagos:₦2,700
Zone A (₦4,568.75):Ekiti, Ogun, Ondo, Osun, Oyo.
Zone B (₦5,643.75):Abia, Anambra, Bayelsa, Delta, Ebonyi, Edo, Enugu, Imo, Kwara, Rivers.
Zone C (₦6,181.25):FCT (Abuja).
Zone D (₦6,450.00):Adamawa, Bauchi, Benue, Borno, Gombe, Jigawa, Kaduna, Kano, Katsina, Kebbi, Kogi, Nasarawa, Niger, Plateau, Sokoto, Taraba, Yobe, Zamfara.
Zone E (₦6,718.75):Akwa Ibom, Cross River.
Estimated Delivery Timelines:Lagos:1 – 2 Business Days.
Rest of Nigeria:3 – 5 Business Days.
Returns & Replacements
AtBrandlistry NG, we stand behind the quality of our products.
Condition:Returns are accepted for products that are unopened, with the original safety seal completely intact.
Damaged Items:If your order is damaged during transit from Lagos, please contact our Customer Care team immediately at+ 23409138179826 or visit us at our Surulere office. We will resolve the issue with a replacement or refund as quickly as possible.
Our Commitment:We aim to provide a stress-free shopping experience. If you have any concerns about your delivery or the product received, our team is ready to assist.
Frequently asked questions
What is Brandlistry?
Brandlistry is Africa’s premier health & beauty marketplace, connecting customers to authentic beauty, skincare, wellness, and personal care products from trusted brands.
Are all products on Brandlistry authentic?
Yes. All products sold on Brandlistry Nigeria are 100% authentic and sourced directly from verified brands, manufacturers, or authorised distributors. We are committed to providing customers with genuine beauty, health, and wellness products.
How long does delivery take within Nigeria?
Orders are shipped from our Lagos warehouse. Estimated delivery times: Lagos: 1 – 2 business days Other states: 3 – 5 business days Delivery timelines may vary depending on your location and logistics conditions.
Do you deliver nationwide?
Yes. Brandlistry Nigeria delivers to all states across Nigeria. Shipping fees vary depending on your location and delivery zone.
How do I know which product is right for me?
Each product page contains detailed information about ingredients, benefits, and recommended use to help you make the best choice. If you need further assistance, you can also reach out to our team or ask a beauty expert through our support channels.
How can I contact customer support?
You can reach our customer care team through: Phone / WhatsApp: +234 913 817 9826 Office Visit: Surulere, Lagos Website Contact Page Our team is available to assist with orders, product questions, and delivery support.
What Our Customers Say
Real stories from real people
"This product exceeded my expectations. The quality is incredible and the customer service was outstanding."